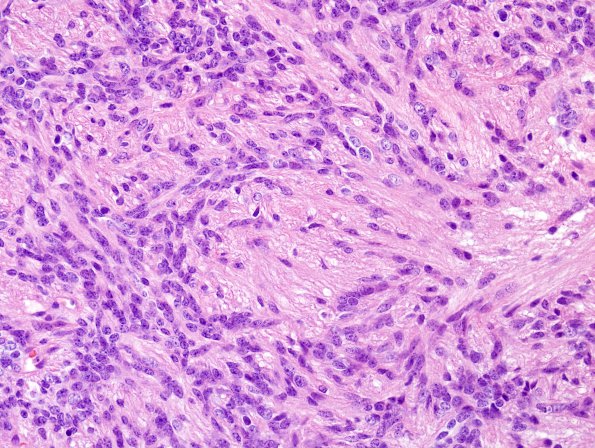
25B4 Ependymoma, focal anaplasia, Grade III (Case 25) H&E 2.jpg

Table of Contents
Washington University Experience | NEOPLASMS (GLIAL) | Ependymoma - Microscopic | 25B4 Ependymoma, focal anaplasia, Grade III (Case 25) H&E 2.jpg
There are patchy areas with increased cellularity and in these areas mitotic figures are frequent (up to 9 mitoses/10HPF).